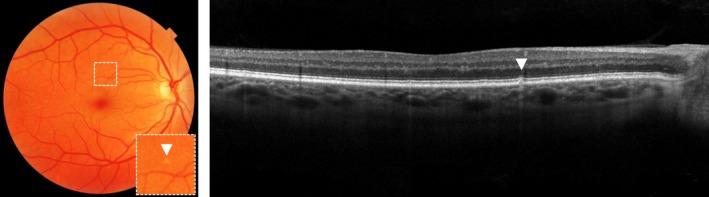
https://cdn.ncbi.nlm.nih.gov/pmc/blobs/d0da/7155063/28c6a7f25c73/OPO-40-140-g001.jpg
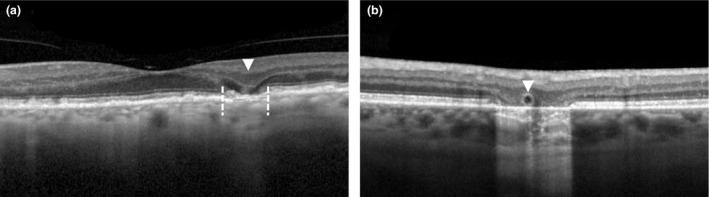
https://cdn.ncbi.nlm.nih.gov/pmc/blobs/d0da/7155063/aa6e6147d952/OPO-40-140-g009.jpg
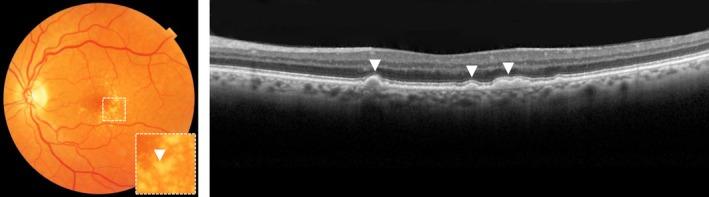
https://cdn.ncbi.nlm.nih.gov/pmc/blobs/d0da/7155063/78175f92f605/OPO-40-140-g002.jpg

与年龄相关的黄斑变性进展的风险因素。
Risk factors for progression of age-related macular degeneration.
机构信息
Departments of, Department of, Ophthalmology, Donders Institute for Brain, Cognition and Behaviour, Radboud University Medical Center, Nijmegen, The Netherlands.
Department of, Human Genetics, Donders Institute for Brain, Cognition and Behaviour, Radboud University Medical Center, Nijmegen, The Netherlands.
出版信息
Ophthalmic Physiol Opt. 2020 Mar;40(2):140-170. doi: 10.1111/opo.12675. Epub 2020 Feb 25.
PURPOSE
Age-related macular degeneration (AMD) is a degenerative disease of the macula, often leading to progressive vision loss. The rate of disease progression can vary among individuals and has been associated with multiple risk factors. In this review, we provide an overview of the current literature investigating phenotypic, demographic, environmental, genetic, and molecular risk factors, and propose the most consistently identified risk factors for disease progression in AMD based on these studies. Finally, we describe the potential use of these risk factors for personalised healthcare.
RECENT FINDINGS
While phenotypic risk factors such as drusen and pigment abnormalities become more important to predict disease progression during the course of the disease, demographic, environmental, genetic and molecular risk factors are more valuable at earlier disease stages. Demographic and environmental risk factors such as age and smoking are consistently reported to be related to disease progression, while other factors such as sex, body mass index (BMI) and education are less often associated. Of all known AMD variants, variants that are most consistently reported with disease progression are rs10922109 and rs570618 in CFH, rs116503776 in C2/CFB/SKIV2L, rs3750846 in ARMS2/HTRA1 and rs2230199 in C3. However, it seems likely that other AMD variants also contribute to disease progression but to a lesser extent. Rare variants have probably a large effect on disease progression in highly affected families. Furthermore, current prediction models do not include molecular risk factors, while these factors can be measured accurately in the blood. Possible promising molecular risk factors are High-Density Lipoprotein Cholesterol (HDL-C), Docosahexaenoic acid (DHA), eicosapentaenoic acid (EPA), zeaxanthin and lutein.
SUMMARY
Phenotypic, demographic, environmental, genetic and molecular risk factors can be combined in prediction models to predict disease progression, but the selection of the proper risk factors for personalised risk prediction will differ among individuals and is dependent on their current disease stage. Future prediction models should include a wider set of genetic variants to determine the genetic risk more accurately, and rare variants should be taken into account in highly affected families. In addition, adding molecular factors in prediction models may lead to preventive strategies and personalised advice.
目的
年龄相关性黄斑变性(AMD)是一种黄斑变性疾病,常导致进行性视力丧失。疾病进展的速度在个体之间可能有所不同,并与多种危险因素相关。在这篇综述中,我们概述了当前研究中表型、人口统计学、环境、遗传和分子危险因素的文献,并根据这些研究提出了 AMD 疾病进展中最一致确定的危险因素。最后,我们描述了这些危险因素在个性化医疗中的潜在用途。
最近的发现
虽然在疾病进程中,大斑和色素异常等表型危险因素对于预测疾病进展变得更加重要,但人口统计学、环境、遗传和分子危险因素在疾病早期阶段更有价值。人口统计学和环境危险因素,如年龄和吸烟,一直被报道与疾病进展有关,而其他因素,如性别、体重指数(BMI)和教育,较少与疾病进展相关。在所有已知的 AMD 变体中,与疾病进展最一致相关的变体是 CFH 中的 rs10922109 和 rs570618、C2/CFB/SKIV2L 中的 rs116503776、ARMS2/HTRA1 中的 rs3750846 和 C3 中的 rs2230199。然而,似乎其他 AMD 变体也可能对疾病进展有一定程度的贡献。在高度受影响的家庭中,罕见变体可能对疾病进展有较大影响。此外,目前的预测模型不包括分子危险因素,而这些因素可以在血液中准确测量。有希望的分子危险因素可能是高密度脂蛋白胆固醇(HDL-C)、二十二碳六烯酸(DHA)、二十碳五烯酸(EPA)、玉米黄质和叶黄素。
总结
表型、人口统计学、环境、遗传和分子危险因素可以结合在预测模型中,以预测疾病进展,但针对个体的个性化风险预测选择适当的危险因素将有所不同,并且取决于他们目前的疾病阶段。未来的预测模型应包括更广泛的遗传变异,以更准确地确定遗传风险,并且在高度受影响的家庭中应考虑罕见变异。此外,在预测模型中添加分子因素可能会导致预防性策略和个性化建议。